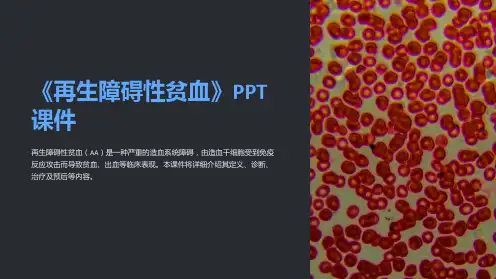

二、骨髓象
正常骨髓象
慢性再障骨髓象
急性再障骨髓象
【诊断】
一、再生障碍性贫血的诊断标准
SAA 1.有典型重型再障临床表现; 2.血象具备下列中的2项: 网织红细胞<1%,绝对值<15×109 白细胞减少,N <0.5×109 血小板<20×109 3.骨髓: 多部位增生减低,三系造血细胞减少,非造血细胞、淋巴细胞和脂肪细胞增多。 NSAA 达不到SAA的诊断标准
一、血象
外周三系减少,淋巴细胞比例升高
SAA骨髓象 多部位骨髓增生重度减低,粒系、红系明显减少且形态大致正常,巨核细胞缺如;淋巴细胞、非造血细胞比例明显增高;骨髓小粒空虚。 骨髓活检:造血组织减少。
二、骨髓象
NSAA骨髓象 多部位骨髓增生减低,粒系、红系减少且形态大致正常,淋巴细胞、网状细胞、浆细胞比例增高,巨核细胞减少;多数骨髓小粒空虚。 骨髓活检:造血组织均匀减少。
再生障碍性贫血 (AA)
再生障碍性贫血(AA),是一种可能由不同病因和机制引起的骨髓造血功能衰竭, 主要表现为 骨髓造血功能低下, 全血细胞减少, 贫血、出血、感染。
再生障碍性贫血的定义
重型再障(SAA) 按照病情分为 非重型再障(NSAA)
血常规:WBC1.6×109, N0.1×109 HB58g/L,PLT10 ×109,RET0.1%,绝对值10×109。 骨髓象:骨髓增生极度低下,巨核细胞未见,粒系0.48,以杆状分叶核为主,红系0.05,成熟红细胞大致正常,成熟L0.39,M0.05,成熟浆细胞0.03。 请回答: 患者目前诊断可能是什么?
分型诊断标准
二、再生障碍性贫血的分型诊断标准
阵发性睡眠性血红蛋白尿(PNH) 1.相同点: ①全血细胞↓ ②可呈骨髓增生低下 ③可无血红蛋白尿的发作 2.不同点: ①典型者有血红蛋白尿发作史、黄疸和脾大 ②溶血试验阳性:ham(酸溶血试验) ③外周血或骨髓可发现CD55、CD59的细胞